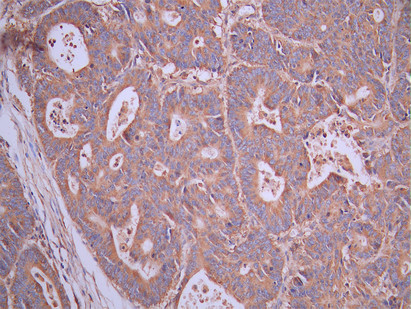

-
中文名稱:ULK1 Recombinant Monoclonal Antibody
-
貨號:CSB-RA057250A0HU
-
規格:¥1320
-
圖片:
-
Western Blot
Positive WB detected in: A549 whole cell lysate(30μg), HEK293 whole cell lysate(30μg), Jurkat whole cell lysate(30μg), MCF-7 whole cell lysate(30μg)
All lanes: ULK1 antibody at 1:1000
Secondary
Goat polyclonal to rabbit IgG at 1/40000 dilution
Predicted band size: 113 kDa
Observed band size: 130 kDa
Exposure time:2min -
IHC image of CSB-RA057250A0HU diluted at 1:100 and staining in paraffin-embedded human skeletal muscle tissue performed on a Leica BondTM system. After dewaxing and hydration, antigen retrieval was mediated by high pressure in a citrate buffer (pH 6.0). Section was blocked with 10% normal goat serum 30min at RT. Then primary antibody (1% BSA) was incubated at 4°C overnight. The primary is detected by a Goat anti-rabbit polymer IgG labeled by HRP and visualized using 0.05% DAB.
-
IHC image of CSB-RA057250A0HU diluted at 1:100 and staining in paraffin-embedded human colorectal cancer performed on a Leica BondTM system. After dewaxing and hydration, antigen retrieval was mediated by high pressure in a citrate buffer (pH 6.0). Section was blocked with 10% normal goat serum 30min at RT. Then primary antibody (1% BSA) was incubated at 4°C overnight. The primary is detected by a Goat anti-rabbit polymer IgG labeled by HRP and visualized using 0.05% DAB.
-
-
其他:
產品詳情
-
Uniprot No.:
-
基因名:
-
別名:ATG 1 antibody; ATG1 antibody; ATG1 autophagy related 1 homolog antibody; ATG1A antibody; Autophagy related protein 1 homolog antibody; Autophagy-related protein 1 homolog antibody; FLJ38455 antibody; FLJ46475 antibody; hATG1 antibody; KIAA0722 antibody; Serine/threonine protein kinase ULK1 antibody; Serine/threonine protein kinase Unc51.1 antibody; Serine/threonine-protein kinase ULK1 antibody; ULK 1 antibody; ULK1 antibody; ULK1_HUMAN antibody; Unc 51 (C. elegans) like kinase 1 antibody; UNC 51 antibody; Unc 51 like kinase 1 antibody; Unc-51 like kinase 1 (C. elegans) antibody; Unc-51-like kinase 1 antibody; UNC51 antibody; UNC51; C. elegans; homolog of antibody; Unc51.1 antibody
-
反應種屬:Human
-
免疫原:A synthesized peptide from human ULK1 protein
-
免疫原種屬:Homo sapiens (Human)
-
標記方式:Non-conjugated
-
克隆類型:Monoclonal
-
抗體亞型:Rabbit IgG
-
純化方式:Affinity-chromatography
-
克隆號:1B2
-
濃度:It differs from different batches. Please contact us to confirm it.
-
保存緩沖液:Rabbit IgG in 10mM phosphate buffered saline , pH 7.4, 150mM sodium chloride, 0.05% BSA, 0.02% sodium azide and 50% glycerol.
-
產品提供形式:Liquid
-
應用范圍:ELISA, WB, IHC
-
推薦稀釋比:
Application Recommended Dilution WB 1:500-1:5000 IHC 1:50-1:200 -
Protocols:
-
儲存條件:Upon receipt, store at -20°C or -80°C. Avoid repeated freeze.
-
貨期:Basically, we can dispatch the products out in 1-3 working days after receiving your orders. Delivery time maybe differs from different purchasing way or location, please kindly consult your local distributors for specific delivery time.
-
用途:For Research Use Only. Not for use in diagnostic or therapeutic procedures.
相關產品
靶點詳情
-
功能:Serine/threonine-protein kinase involved in autophagy in response to starvation. Acts upstream of phosphatidylinositol 3-kinase PIK3C3 to regulate the formation of autophagophores, the precursors of autophagosomes. Part of regulatory feedback loops in autophagy: acts both as a downstream effector and negative regulator of mammalian target of rapamycin complex 1 (mTORC1) via interaction with RPTOR. Activated via phosphorylation by AMPK and also acts as a regulator of AMPK by mediating phosphorylation of AMPK subunits PRKAA1, PRKAB2 and PRKAG1, leading to negatively regulate AMPK activity. May phosphorylate ATG13/KIAA0652 and RPTOR; however such data need additional evidences. Plays a role early in neuronal differentiation and is required for granule cell axon formation. May also phosphorylate SESN2 and SQSTM1 to regulate autophagy. Phosphorylates FLCN, promoting autophagy. Phosphorylates AMBRA1 in response to autophagy induction, releasing AMBRA1 from the cytoskeletal docking site to induce autophagosome nucleation.
-
基因功能參考文獻:
- Our results suggest that ULK1 is upregulated in Clear Cell Renal Carcinoma tumors and may be a potential therapeutic target. PMID: 30078736
- the nucleation of autophagosomes occurs in endoplasmic reticulum tubulovesicular regions, where the ULK1 complex coalesces with ER and the ATG9 compartment PMID: 27510922
- rs9652059 variation (C-->T) could increase AS susceptibility and haplotypes of rs9652059(C)-rs4964879(G), rs9652059(C)-rs11616018(T) and rs9652059(T)-rs11616018(T) may be associatd with AS in a Chinese Han population. PMID: 28667165
- Simultaneous high expression of ULK1 (and LC3B) had a poorer overall survival rate in hepatocellular cancer patients. PMID: 29091866
- Authors conclude that miR-93 is involved in hypoxia-induced autophagy by regulating ULK1. Results provide a new angle to understand the complicated regulation of the key autophagy kinase ULK1 during different stress conditions. PMID: 29109831
- this study found that upregulation of MACC1 in ESCC was associated with lymph node metastasis of patients, and MACC1 regulated ESCC cell proliferation, apoptosis, migration and invasion mainly through AMPK-ULK1 induced autophagy PMID: 28791376
- ULK1 phosphorylation at 3 different sites on the same ULK1 target region for NEDD4L is preparatory for its ubiquitylation and subsequent degradation. PMID: 28820317
- Activation of autophagy can attenuate accumulation of LPL, thereby limiting fatty acid excess, and prevent cardiac dysfunction in obese hearts via ULK1. PMID: 28430962
- Overexpression of unc-51 like autophagy activating kinase causes elevated autophagy and aggregation of the ER exit sites(ERES), a region of the ER dedicated for the budding of COPII vesicles. Transport of cargo proteins is therefore inhibited and is retained at the ERES. PMID: 28486929
- silencing of HOTAIR decreased drug resistance of Non-Small Cell Lung Cancer cells to Crizotinib through inhibition of autophagy via suppressing phosphorylation of ULK1. PMID: 29470986
- CLDN1 activates autophagy through up-regulation of ULK1 phosphorylation and promotes drug resistance of non-small cell lung cancer cells to cisplatin. PMID: 28614291
- These findings revealed that prosurvival autophagy was one of the mechanisms involved in the resistance acute myeloid leukemia (AML) leukemia stem cells to JQ1. Targeting the AMPK/ULK1 pathway or inhibition of autophagy could be an effective therapeutic strategy for combating resistance to BET inhibitors in AML and other types of cancer PMID: 27864418
- we demonstrate that Ulk1 over-expression in human gastric cancer is pro-survival. Its over-expression is associated with patients' T classification and cancer relapse. PMID: 28410240
- our results show that inhibition of Ulk1 suppresses Non-small cell lung cancer (NSCLC)cell growth and sensitizes NSCLC cells to cisplatin by modulating both autophagy and apoptosis pathways, and that Ulk1 might be a promising target for NSCLC treatment. PMID: 28498429
- review the diverse roles of ULK1, with special focus on its importance to type I IFN signaling, and highlight important future study questions. PMID: 27068414
- ULK1 played a crucial role in ALDH2-offered protective effect against high glucose exposure-induced cardiomyocyte injury through regulation of autophagy PMID: 29128638
- Lack of mitochondrial DNA impairs chemical hypoxia-induced autophagy in liver tumor cells through reactive oxygen species-AMPK-ULK1 signaling dysregulation independently of HIF-1A. PMID: 27687210
- phosphorylation of mATG9 at Tyr8 by Src and at Ser14 by ULK1 functionally cooperate to promote interactions between mATG9 and the AP1/2 complex. PMID: 27934868
- we found that ATG14 interacted with Ulk1 and LC3, and knock down of Ulk1 prevented the lipidation of LC3 and autophagy in HeLa-ATG14 cells. We also identified a phosphatidylethanolamine (PE) binding region in ATG14, and the addition of Ulk1 to Hela-ATG14 cells decreased the ATG14-PE interaction. PMID: 28069524
- Data show that ULK1, a protein kinase activated at the autophagosome formation site, phosphorylates human ATG4B on serine 316. PMID: 28821708
- While focusing on the role of SMCR8 during autophagy initiation, we found that kinase activity and gene expression of ULK1 are increased upon SMCR8 depletion. The latter phenotype involved association of SMCR8 with the ULK1 gene locus. PMID: 28195531
- despite the significant upregulation of mRNA of the essential autophagy initiation gene ULK1, its protein level is rapidly reduced under starvation. PMID: 27629431
- Our findings demonstrate for the first time that miR-26a/b can promote apoptosis and sensitize Hepatocellular carcinoma (HCC) to chemotherapy via suppressing the expression of autophagy initiator ULK1, and provide the reduction of miR-26a/b in HCC as a novel mechanism of tumor chemoresistance. PMID: 28079894
- Downregulation of ULK1 inhibited the overexpression effects of miR-372, and upregulation of ULK1 reversed the effects of overexpressed miR-372 in human pancreatic adenocarcinoma cells. PMID: 28677209
- These findings reveal that Endoplasmic reticulum stress engages the GSK3beta-TIP60-ULK1 pathway to increase autophagy. PMID: 28032867
- ULK1/2 function as a bifurcate-signaling node that sustains glucose metabolic fluxes besides initiation of autophagy in response to nutritional deprivation. PMID: 27153534
- these results demonstrate the effective anti-autophagic of NRAGE in non-small-cell lung cancer cells through AMPK/Ulk1/Atg13 autophagy signaling pathways. Therefore, NRAGE could be used as a potential therapeutic target for lung cancer. PMID: 28639909
- results from western blotting assays and immunoprecipitation assays displayed that sirtuin 6 specifically interacted with ULK1 and positively regulated its activity by inhibiting its upstream factor mammalian target of rapamycin activity. PMID: 28653878
- As a Rab1a effector, C9orf72 controls initiation of autophagy by regulating the Rab1a-dependent trafficking of the ULK1 autophagy initiation complex to the phagophore. PMID: 27334615
- Ulk1 promoted the degradation of Hsp90-Cdc37 client kinases, resulting in increased cellular sensitivity to Hsp90 inhibitors. Thus, our study provides evidence for an anti-proliferative role of Ulk1 in response to Hsp90 inhibition in cancer cells PMID: 28073914
- Here, the authors demonstrate that S100A10 is required for ULK1 localization to autophagosome formation sites. Silencing of S100A10 reduces IFN-gamma-induced autophagosome formation. PMID: 27871932
- A strong association of rs12297124, a noncoding ULK1 SNP, with LTBI and a role for ULK1 regulation of TNF secretion. PMID: 27485354
- High expression of ULK1 concomitant with high expression of LRPPRC may serve as useful markers for shorter biochemical progression (BCP)-free survival and overall survival in patients with metastatic prostate cancer (PCa) after androgen deprivation therapy (ADT). PMID: 27679555
- These results thus place NEDD4L and ULK1 in a key position to control oscillatory activation of autophagy during prolonged stress to keep the levels of this process under a safe and physiological threshold. PMID: 27932573
- These results demonstrate a novel mechanism by which STAT1 negatively regulates ULK1 expression and autophagy. PMID: 28011640
- These results show that the SiMoA technology can detect quantitatively low levels of endogenous biomarkers with the ability to detect the loss of pSer(318)-Atg13 upon ULK1 inhibition. PMID: 27387056
- The newly developed ULK1 PCR assay was applied to genotype samples from 100 healthy individuals of North Indian origin. Genotype frequencies were 9, 34 and 57 % for GG, GT and TT, respectively. Allele frequencies were 0.26 and 0.74 for G and T, respectively. The allele frequencies were in Hardy-Weinberg's equilibrium (p = 0.2443). PMID: 27783190
- These results define a key molecular event for the starvation-induced activation of the ATG14-containing PtdIns3K complex by ULK1. PMID: 27046250
- Knockdown of either ULK1 or DLP1 expression with shRNAs suppresses LRRK2 G2019S expression-induced mitochondrial clearance, suggesting that LRRK2 G2019S expression induces mitochondrial fission through DLP1 followed by mitophagy via an ULK1 dependent pathway. PMID: 27023913
- Of several factors examined, bone metastasis, liver metastasis, and ULK1 expression were shown to have significant effects on the response to mTOR inhibitors. PMID: 26299883
- ULK1 could inhibit p70S6K in starvation-induced autophagy, and further identified that miR-4487 and miR-595 were novel ULK1 target miRNAs PMID: 26183158
- Structure of the human Atg13-Atg101 HORMA heterodimer in the ULK1 complex that controls autophagy has been described. PMID: 26299944
- MUL1 ubiquitinates ULK1 and regulates selenite-induced mitophagy PMID: 26018823
- the inhibition of deubiquitinases by the compound WP1130 leads to increased ULK1 ubiquitination, the transfer of ULK1 to aggresomes, and the inhibition of ULK1 activity. PMID: 26207339
- ROS-AMPK-ULK1 mechanism that couples T3-induced mitochondrial turnover with activity, wherein mitophagy is necessary not only for removing damaged mitochondria but also for sustaining efficient OXPHOS PMID: 26103054
- Study identifies a key role of Cul3-KLHL20 in autophagy termination by controlling autophagy-dependent turnover of ULK1 and VPS34 complex subunits and reveals the pathophysiological functions of this autophagy termination mechanism. PMID: 26687681
- Findings highlight a cytoprotective role of p32 under starvation conditions by regulating ULK1 stability, and uncover a crucial role of the p32-ULK1-autophagy axis in coordinating stress response, cell survival and mitochondrial homeostasis. PMID: 25909887
- Concurrent mTORC1 inactivation and PP2A-B55alpha stimulation fuel ULK1-dependent autophagy. PMID: 26310906
- ULK1-mediated autophagy has a role in retinoic acid-induced IgG production in TLR9-activated human primary B cells PMID: 25749095
- a novel signaling pathway identified whereby starvation-induced activation of ULK leads to phosphorylation of endogenous DENND3, with subsequent activation of Rab12 and initiation of membrane trafficking events required for autophagy PMID: 25925668
顯示更多
收起更多
-
亞細胞定位:Cytoplasm, cytosol. Preautophagosomal structure.
-
蛋白家族:Protein kinase superfamily, Ser/Thr protein kinase family, APG1/unc-51/ULK1 subfamily
-
組織特異性:Ubiquitously expressed. Detected in the following adult tissues: skeletal muscle, heart, pancreas, brain, placenta, liver, kidney, and lung.
-
數據庫鏈接:
Most popular with customers
-
-
YWHAB Recombinant Monoclonal Antibody
Applications: ELISA, WB, IHC, IF, FC
Species Reactivity: Human, Mouse, Rat
-
Phospho-YAP1 (S127) Recombinant Monoclonal Antibody
Applications: ELISA, WB, IHC
Species Reactivity: Human
-
-
-
-
-